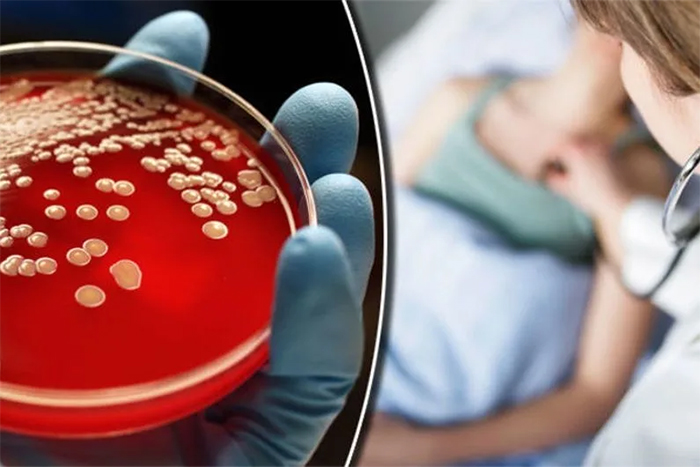

Пауки-фаланги, или опистотонты, — уникальная группа паукообразных с характерной формой тела и поведением. Эти существа интересуют не только биологов, но и широкую аудиторию благодаря своим необычным особенностям и среде обитания. В статье рассмотрим, кто такие пауки-фаланги, их характеристики, места обитания и потенциальную опасность для человека. Знание о них поможет развеять мифы и страхи, а также повысить осведомленность о их роли в экосистеме.
Пауки фаланги — описание и особенности
Фаланги представляют собой не единый вид паукообразных, а целую группу, насчитывающую около 1000 различных разновидностей. На изображениях они могут показаться пугающими — это крупные пауки с устрашающими челюстями. Их тело и конечности покрыты редкими длинными волосками, чаще всего светлого оттенка. Взрослая особь в среднем достигает 5–7 см в длину.
Среди наиболее распространенных видов можно выделить следующие:
- Фаланга обыкновенная — имеет спинку бурого или серого цвета и желтоватое брюшко. Основной рацион состоит из скорпионов и других членистоногих.
- Фаланга закаспийская — отличается буро-рыжей спинкой и серым брюшком, достигает примерно 8 см в длину. Встречается преимущественно в Кыргызстане и Казахстане.
- Фаланга дымчатая — самый крупный представитель своего рода, обитающий в Туркменистане. Характеризуется оливково-дымчатой окраской.
Первое, что привлекает внимание при взгляде на этого паука, — это его передние хелицеры, вызывающие страх и трепет. Каждая из них состоит из двух частей, между которыми находятся суставы. Благодаря такой анатомии, челюсти паука напоминают клешни. На хелицерах расположены зубы, количество которых варьируется в зависимости от вида.
У фаланг десять конечностей. Их органами осязания служат педипальпы, обладающие высокой чувствительностью. Эти пауки мгновенно реагируют на любое движение. Брюшко состоит из десяти сегментов и имеет веретенообразную форму. Грудная часть и голова отделены от тела, что является примитивной чертой. Также стоит отметить, что у пауков-фаланг хорошо развита дыхательная система, что объясняется наличием мелких сосудов с утолщенными стенками и развитыми продольными органами.
Интересно! Домашние пауки: основные виды, опасность и способы борьбы.
Пауки-фаланги, относящиеся к классу паукообразных, вызывают интерес у специалистов благодаря своей уникальной анатомии и поведению. Эксперты отмечают, что эти существа обладают характерной длинной и тонкой формой тела, что позволяет им эффективно передвигаться по различным поверхностям. Их восемь конечностей, которые могут достигать значительной длины, служат не только для передвижения, но и для охоты. Пауки-фаланги активно используют свои ноги для ловли добычи, что делает их эффективными хищниками в экосистемах, где они обитают. Кроме того, специалисты подчеркивают важность этих пауков в контроле численности насекомых, что способствует поддержанию экологического баланса. Несмотря на свою устрашающую внешность, пауки-фаланги не представляют опасности для человека и играют важную роль в биосфере.

Образ жизни паука-фаланги
Пауки-фаланги — это ночные хищники. Они выходят на охоту в темное время суток. Эти членистоногие питаются разными жуками, мелкими пауками, термитами, муравьями и другими ползающими насекомыми. Более крупные виды фалангов могут напасть на агаму, детеныша полевки или маленькую ящерку. Свою добычу они хватают молниеносно, крепко держат ее и разрывают хелицерами.
Некоторые виды способны нападать на птиц. Они срезают оперение и дробят кости на мелкие части. В конце очистки жертвы паук смачивает ее пищеварительным соком и проглатывает. В Америке был обнаружен вид фаланг, которые поедают пчел. Их называют «опустошители ульев». У паука-фаланга есть интересная черта — прожорливость. Иногда они наедаются так, что их брюшко лопается. В этот момент паук начинает умирать, но все еще продолжает поглощать пищу.
Процесс спаривания у этих пауков происходит только ночью. Самец находит самку по запаху. Когда это произошло, он выпускает на землю клейкое вещество, в котором содержится сперма. После самец передает ее самке через половое отверстие с помощью хелицер. После окончания процесса самцу необходимо быстро покинуть место спаривания. Самка в этот момент находится в разъяренном состоянии, поэтому может укусить его или даже съесть.
В период беременности самка фаланги занимается сооружением жилища сама. Там она откладывает яйца. Их количество может варьироваться от 30 до 200. Все зависит от возраста и вида самки. Скорлупа яиц очень тонкая, детеныши вылупляются неподвижные. Двигаться они начинают только со второй недели жизни.
| Характеристика | Описание | Примечание |
|---|---|---|
| Научное название | Solifugae | Также известны как солнечные пауки или верблюжьи пауки |
| Размер тела | 5-70 мм | В зависимости от вида |
| Тело | Длинное, разделено на головогрудь и брюшко | Головогрудь покрыта хитином |
| Хелицеры | Крупные, мощные, клешневидные | Используются для захвата и измельчения добычи |
| Педипальпы | Длинные, похожие на ноги, с чувствительными волосками | Используются для ощупывания и захвата добычи |
| Ноги | 8 ног, длинные и тонкие | Быстро бегают |
| Глаза | 2-8 глаз, простого строения | Плохое зрение |
| Питание | Насекомые, другие беспозвоночные | Хищники |
| Яд | Не ядовиты | Укус болезненный из-за мощных хелицер |
| Среда обитания | Засушливые и полузасушливые регионы | Предпочитают теплый климат |
| Распространение | По всему миру, кроме Антарктиды | Наиболее распространены в тропических и субтропических регионах |
Интересные факты
Вот несколько интересных фактов о пауках-фалангах:
-
Уникальная анатомия: Пауки-фаланги (или пауки-скрипачи) имеют характерное строение тела, которое включает длинные ноги и плоское тело. Их размер может варьироваться от нескольких миллиметров до нескольких сантиметров в длину, а размах ног может достигать 15 см. Это делает их одними из самых крупных пауков в мире.
-
Яд и его свойства: Несмотря на то, что пауки-фаланги обладают ядовитыми железами, их яд не опасен для человека. Укус может вызвать лишь легкое покраснение и зуд, но не представляет серьезной угрозы. Это делает их менее опасными по сравнению с другими видами пауков.
-
Способность к маскировке: Пауки-фаланги обладают выдающейся способностью к маскировке. Их окраска и форма тела помогают им сливаться с окружающей средой, что делает их трудными для обнаружения хищниками и потенциальными жертвами. Это адаптивное поведение помогает им выживать в дикой природе.

Где обитают пауки-фаланги
Эти членистоногие предпочитают обитать в условиях сухого и жаркого климата. Наиболее благоприятными для них являются тропические, субтропические и умеренные зоны. Их можно чаще всего встретить в степных, пустынных или полупустынных областях. Некоторые виды также обитают в лесах. Они отсутствуют только на материковой части Австралии. Ареал обитания фалангов включает:
- Пакистан;
- Индию;
- Бутан;
- Шри-Ланку;
- Африку;
- Испанию;
- Францию;
- Португалию;
- Грецию;
- Болгарию;
- Албанию;
- Турцию.
Интересный факт! Сколько ног у паука?
Чем опасен паук-фаланга для человека
Фаланги не являются ядовитыми пауками, но их укус может иметь тяжелые последствия для организма. Крупные особи могут легко прокусить кожу человека, что зачастую приводит к заражению крови (сепсис). Несмотря на достижения медицины, это является одной из самых распространенных причин смерти в России. Ежегодно умирают порядка 70 000 человек. Это третья по значимости причина смерти после сердечно-сосудистых заболеваний и рака.
Симптомы заражения крови диагностировать непросто. Они схожи с проявлениями гриппа. Если сепсис не распознать вовремя, шансы на выживание невелики. Проблема в том, что многие врачи неправильно интерпретируют симптомы. Пациенты думают, что у них обычный грипп, время на лечение из-за этого тратится впустую. Поэтому к симптомам, возникающим внезапно и бурно после укуса паука-фаланги, нужно относиться серьезно.
В список входят:
- озноб;
- высокая температура;
- тахикардия;
- нарушения памяти и восприятия.
Интересно! Как избавиться от сороконожек

Что делать если укусил паук-фаланга
Если вас укусил паук-фаланга и вы заметили хотя бы один из признаков заражения крови, немедленно обратитесь к врачу. Сепсис представляет собой серьезную угрозу и требует оперативного лечения. Эффективная терапия — единственный способ остановить воспалительный процесс.
Лекарственные средства, применяемые при сепсисе, направлены на уничтожение инфекционных агентов в крови. При укусах паука-фаланги пострадавшим в первую очередь назначают антибиотики широкого спектра действия. Обычно их вводят в высоких дозах через инфузию. Исследования показывают, что каждая потеря времени в начале лечения увеличивает риск летального исхода на восемь процентов за каждый час, пока пациент не получил антибиотик. В процессе терапии необходимо каждые 2–3 дня проверять эффективность назначенных препаратов.
Без должного лечения заражение крови прогрессирует и проходит несколько стадий.
- Сепсис. Иммунная система реагирует на инфекционное воспаление, охватывающее все тело. Для этой стадии характерно наличие как минимум двух из следующих симптомов: высокая температура или понижение температуры, учащенное сердцебиение, учащенное дыхание; изменение уровня лейкоцитов (лейкоцитоз или лейкопения).
- Тяжелый сепсис. Снижение артериального давления приводит к изменению кровообращения и увеличивает риск тромбообразования. Это может вызвать закупорку сосудов, что приводит к недостатку кислорода в органах и нарушению их функций, так как клетки не могут выжить без кислорода и погибают. При тяжелом сепсисе по крайней мере один орган будет ограничен в своей функции.
- Септический шок. Если артериальное давление остается слишком низким, несмотря на проводимое лечение, а сердце не справляется с обеспечением органов необходимым количеством кислорода, возникает септический шок. Эта стадия крайне опасна для жизни и может привести к недостаточности кровообращения, коме и серьезным повреждениям органов в долгосрочной перспективе. Около 60% пациентов не выживают после септического шока.
Заражение крови может быстро вызвать серьезные осложнения. Поскольку инфекция распространяется по кровотоку, она может быстро достичь жизненно важных органов. Легкие, сердце и печень могут быть поражены всего за несколько часов, что может привести к циркуляторному шоку, а также к почечной, легочной и печеночной недостаточности.
Основное внимание в интенсивной терапии уделяется не только борьбе с инфекцией, но и поддержанию функций органов. Часто пациентов вводят в искусственную кому. Даже если сепсис удается преодолеть, многие пациенты сталкиваются с длительными последствиями.
После пробуждения от искусственной комы, продолжавшейся несколько недель, многие пациенты не могут сразу двигаться. Каждое движение требует повторного обучения, а поврежденные органы должны постепенно восстанавливать свою функциональность.
Иногда конечности страдают от недостатка кислорода во время сепсиса, что может привести к отмиранию тканей и необходимости хирургического вмешательства. Это может закончиться ампутацией. Однако чаще возникают отдаленные последствия сепсиса, причины которых не всегда ясны. К ним относятся: потеря веса и работоспособности, повышенная утомляемость, головные боли, боли в суставах и мышцах, а также когнитивные расстройства. Некоторые выжившие после сепсиса сталкиваются с проблемами концентрации, потерей памяти, глухотой и параличом. Вероятно, это связано с повреждением нейронов, вызванным токсинами, падением артериального давления или попаданием воспалительных веществ в мозг.
После выхода из комы у некоторых пациентов может развиться посттравматическое стрессовое расстройство, проявляющееся тревогой, галлюцинациями и ночными кошмарами.
Если ознакомиться с описанием паука-фаланги, можно подумать, что это существо пришло с другой планеты. Более подробно о нем можно узнать в Википедии, а фотографии этого членистоногого доступны в интернете. Будьте осторожны, если встретите его на улице, и не подходите слишком близко, так как укус этого паука может привести к серьезному заболеванию — заражению крови.
Размножение и жизненный цикл пауков-фалангов
Пауки-фаланги, относящиеся к отряду Opiliones, имеют уникальный жизненный цикл и особенности размножения, которые отличают их от других пауков. Эти существа известны своим характерным внешним видом, который включает в себя длинные ноги и компактное тело, но их репродуктивные привычки и жизненные этапы также заслуживают внимания.
Размножение пауков-фалангов происходит в основном в теплое время года, когда условия для спаривания наиболее благоприятны. Самцы привлекают самок с помощью различных ритуалов, которые могут включать в себя танцы, вибрации или выделение феромонов. После успешного привлечения самки, самец осуществляет спаривание, которое может длиться от нескольких минут до нескольких часов. Важно отметить, что в некоторых видах самцы могут проявлять агрессию к самкам, что иногда приводит к каннибализму.
После спаривания самка откладывает яйца в защищенное место, обычно в трещины коры деревьев, под камнями или в других укрытиях. Яйца помещаются в коконы, которые обеспечивают защиту от хищников и неблагоприятных условий окружающей среды. Количество яиц может варьироваться в зависимости от вида, но обычно составляет от нескольких десятков до нескольких сотен.
Жизненный цикл пауков-фалангов включает в себя несколько стадий. После вылупления из яиц, молодые пауки проходят стадию нимфы, которая напоминает взрослую особь, но отличается меньшими размерами и отсутствием половых признаков. Нимфы линяют несколько раз, постепенно увеличивая свои размеры и развивая половые органы. Этот процесс может занять от нескольких месяцев до нескольких лет, в зависимости от условий окружающей среды и доступности пищи.
Взрослые пауки-фаланги достигают половой зрелости в возрасте от одного до трех лет. Они могут жить до 5-7 лет, в зависимости от вида и условий обитания. Взрослые особи ведут одиночный образ жизни и активно охотятся на мелких беспозвоночных, таких как насекомые и черви. Важно отметить, что пауки-фаланги не плетут паутины, как многие другие пауки, а используют свои длинные ноги для ловли добычи.
Таким образом, размножение и жизненный цикл пауков-фалангов представляют собой сложный и интересный процесс, который включает в себя множество этапов и адаптаций, позволяющих этим существам выживать в различных условиях. Их уникальные репродуктивные стратегии и жизненные привычки делают их важной частью экосистемы и объектом изучения для биологов и энтомологов.
Вопрос-ответ
Чем питаются пауки фаланги?
Все фаланги очень подвижны, и почти все они — ночные хищники. Фаланги плотоядны или всеядны, питаются термитами, пчелами, жуками-чернотелками и другими мелкими членистоногими, но также могут употреблять в пищу более крупных животных, например, ящериц. Фаланги предпочитают засушливый климат и пустынную местность.
Как выглядит фаланга?
Каждая фаланга представляет собой удлинённую косточку, имеющую в средней части (диафиз) форму полуцилиндра, плоская часть которого обращена на ладонную, а выпуклая на тыльную сторону. Концевые части фаланги (эпифизы) несут суставные поверхности.
На сколько метров прыгает фаланга?
Все фаланги очень подвижны, а отдельные особи могут развивать скорость до 16 км/ч. Они легко взбираются по вертикальным поверхностям и могут прыгать на значительное расстояние (крупные виды более метра в длину и до двух метров в высоту).
Советы
СОВЕТ №1
Изучите среду обитания пауков-фалангов, чтобы лучше понять их поведение и привычки. Эти пауки предпочитают влажные места, поэтому их можно часто встретить в садах, лесах и даже в домах. Знание их предпочтений поможет вам избежать нежелательных встреч.
СОВЕТ №2
Обратите внимание на особенности внешнего вида пауков-фалангов. Они имеют характерные длинные ноги и плоское тело, что помогает им легко передвигаться по поверхности. Умение распознавать их по внешним признакам поможет вам отличить их от других видов пауков.
СОВЕТ №3
Если вы хотите завести паука-фаланга в качестве домашнего питомца, убедитесь, что вы создали для него подходящие условия. Это включает в себя правильный террариум, уровень влажности и температуру, а также подходящий рацион питания. Правильный уход обеспечит здоровье и долголетие вашего питомца.
СОВЕТ №4
Не забывайте о безопасности. Хотя пауки-фаланги не представляют серьезной угрозы для человека, их укус может вызвать дискомфорт. Если вы столкнулись с пауком, лучше всего не трогать его и дать ему возможность уйти самостоятельно.